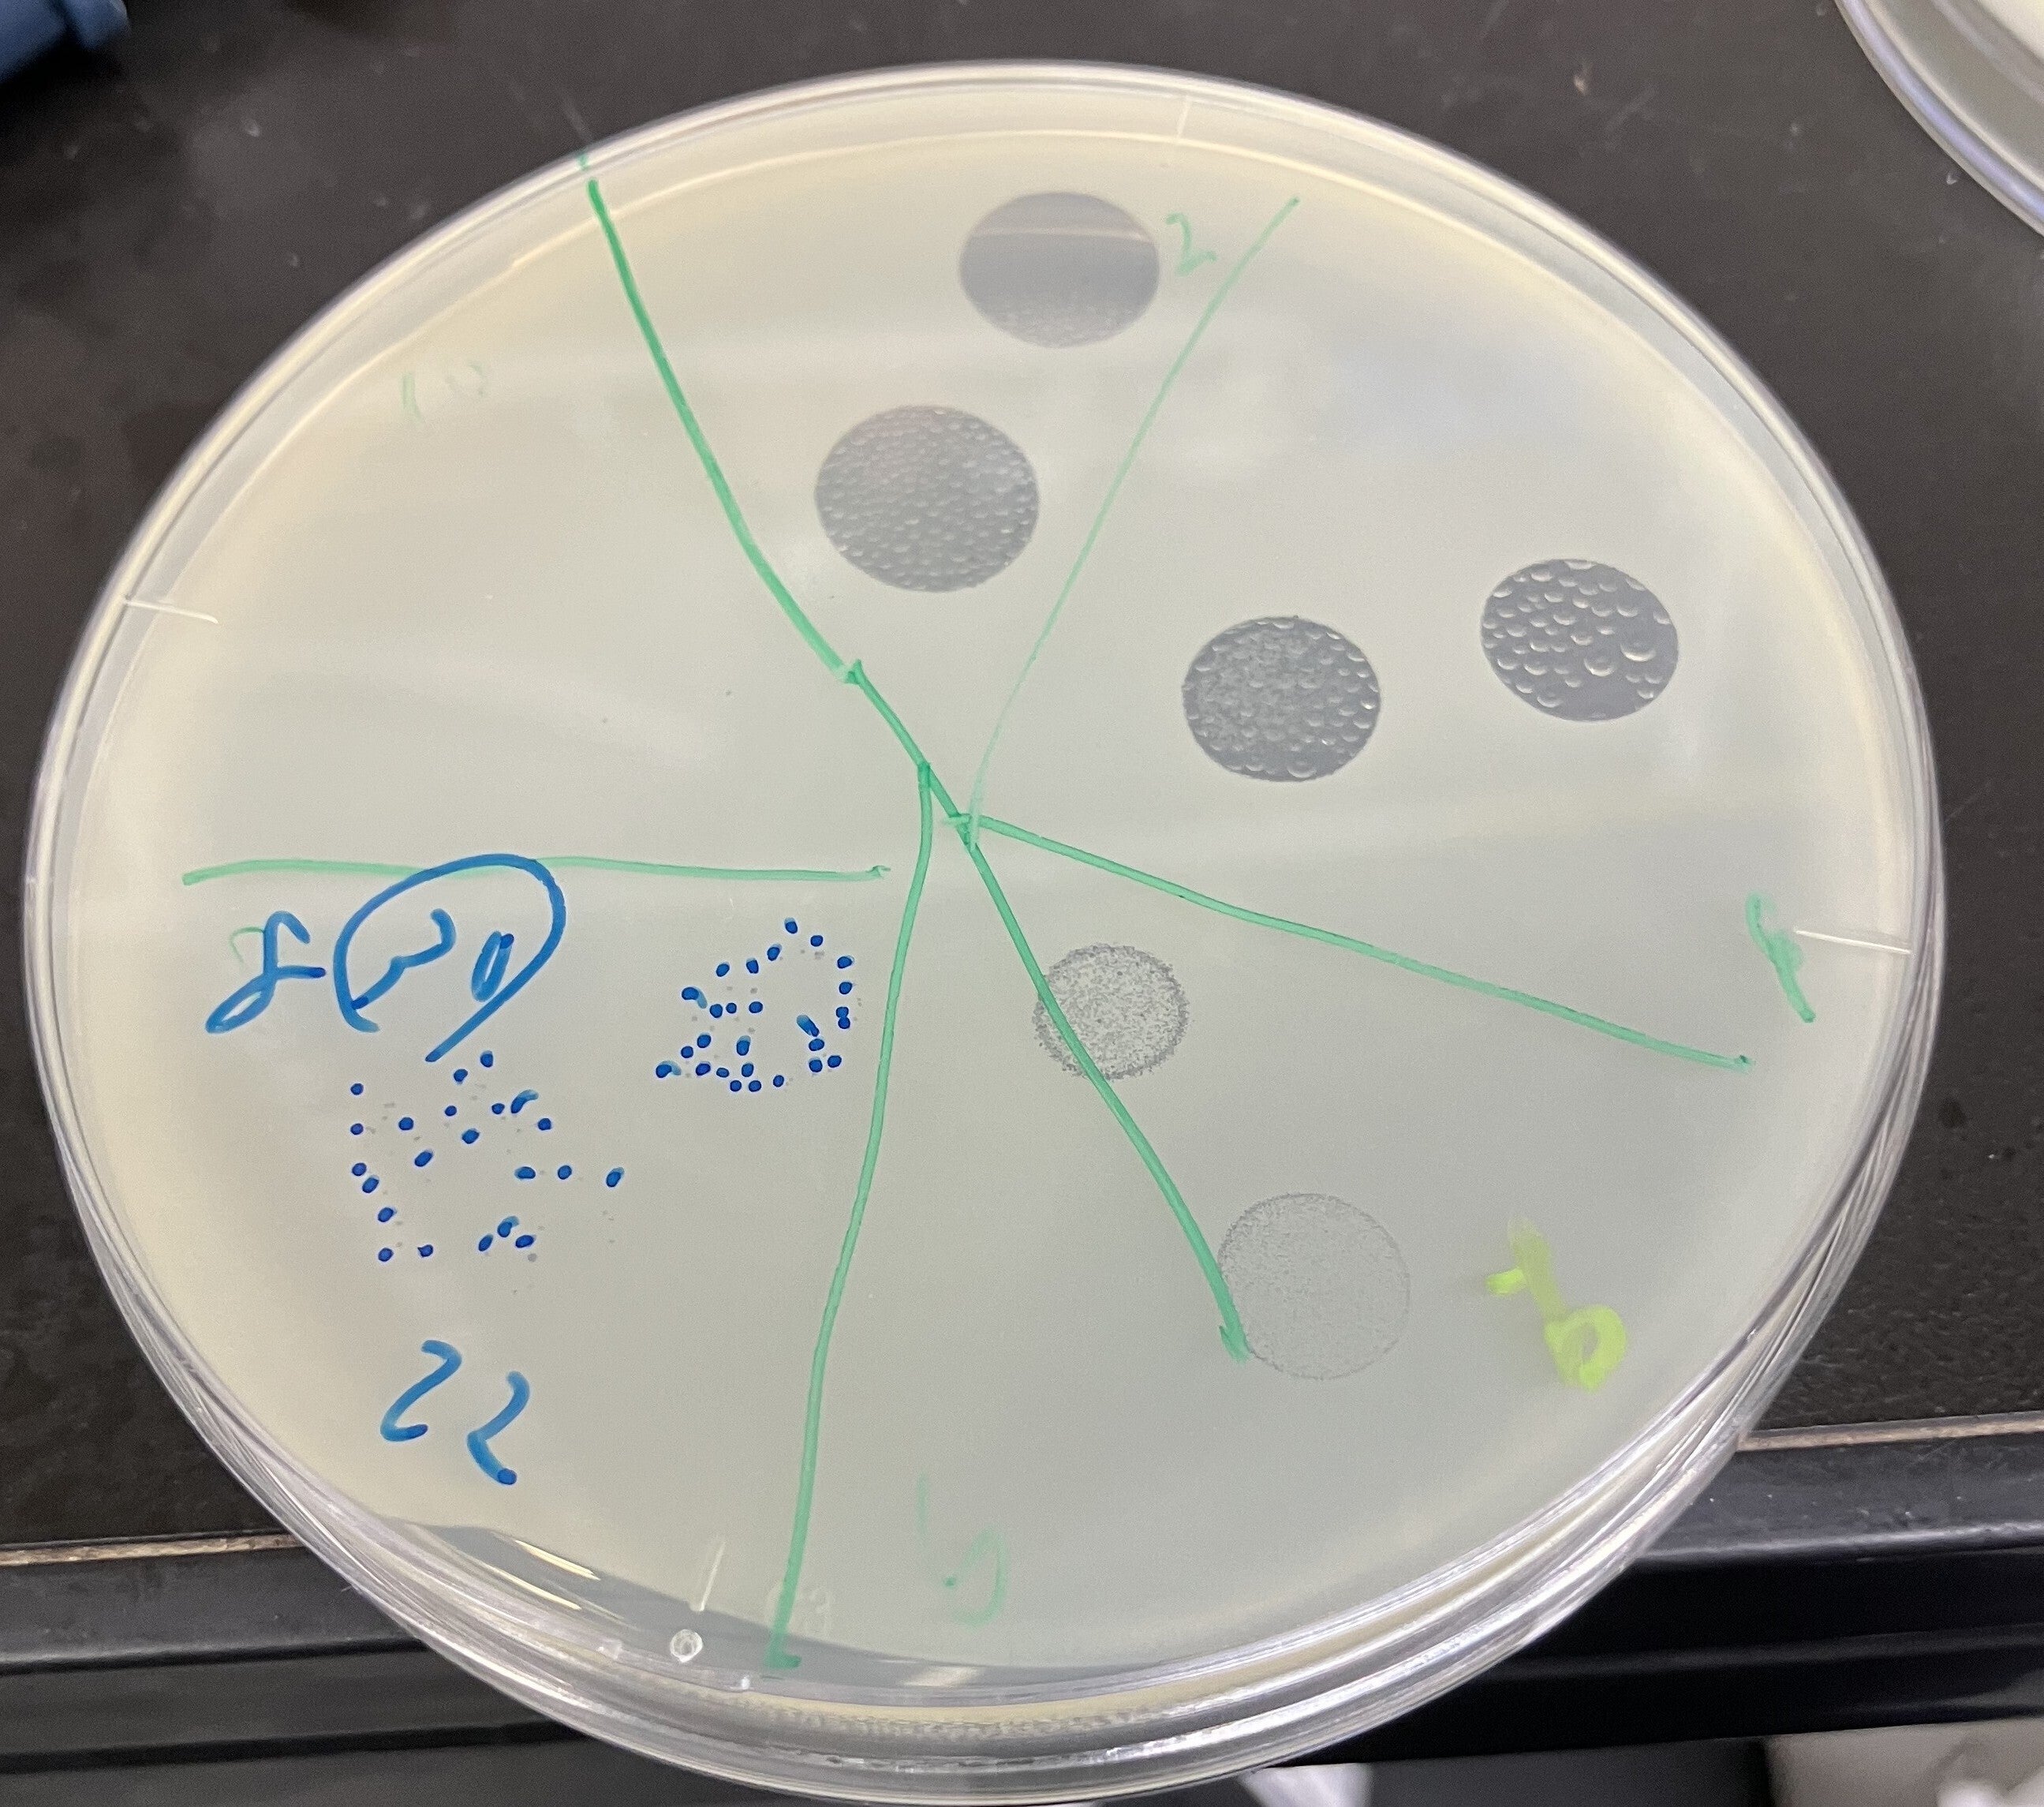

20%まで達成することが出来ました!
クラウドファンディングにご支援賜り誠にありがとうございます。
代表の北岡です。
今回は、どうやって、バクテリオファージを入手していったかについてお話します。
バクテリオファージは、身の回りどこにでもいます。
バクテリオファージは菌の周りにいるので、菌が沢山いるところに多くいます。
なので、世界のファージ研究者が一番使っているのが下水です。
下水をもってきて、菌に振りかけて、バクテリオファージを取り出すのが主流です。
今回のバクテリオファージも下水から見つかりました。
そう聞くと、汚い!と思ってしまいますが、そこは安心してください。
見つけた後の、バクテリオファージの増幅は、工場で行い、下水は一切関係ありません!
実際、世界に目を向けると、実は、バクテリオファージは製品として導入されています。
アメリカでは、ニキビ対策の化粧品や、ソーセージの加工の際に使われています。
東欧では、実際に、治療薬として薬局で売られていたりもします。
これらのバクテリオファージも元は、どこかの下水からとれたバクテリオファージだったりします。
どこの下水か、そして時期によって、異なるバクテリオファージが取れます。
なので、ポケモンにたとえられることが多いです。
場所によって、違うものが取れる。ロマンがあります!
もっと良いバクテリオファージが取れる可能性もあり、日々採取して、実験しています。
クラウドファンディングの資金はこの研究費にも使用します。
よろしくお願いいたします。
良いバクテリオファージファージが取れて、良い報告が出来るよう、頑張ります!



